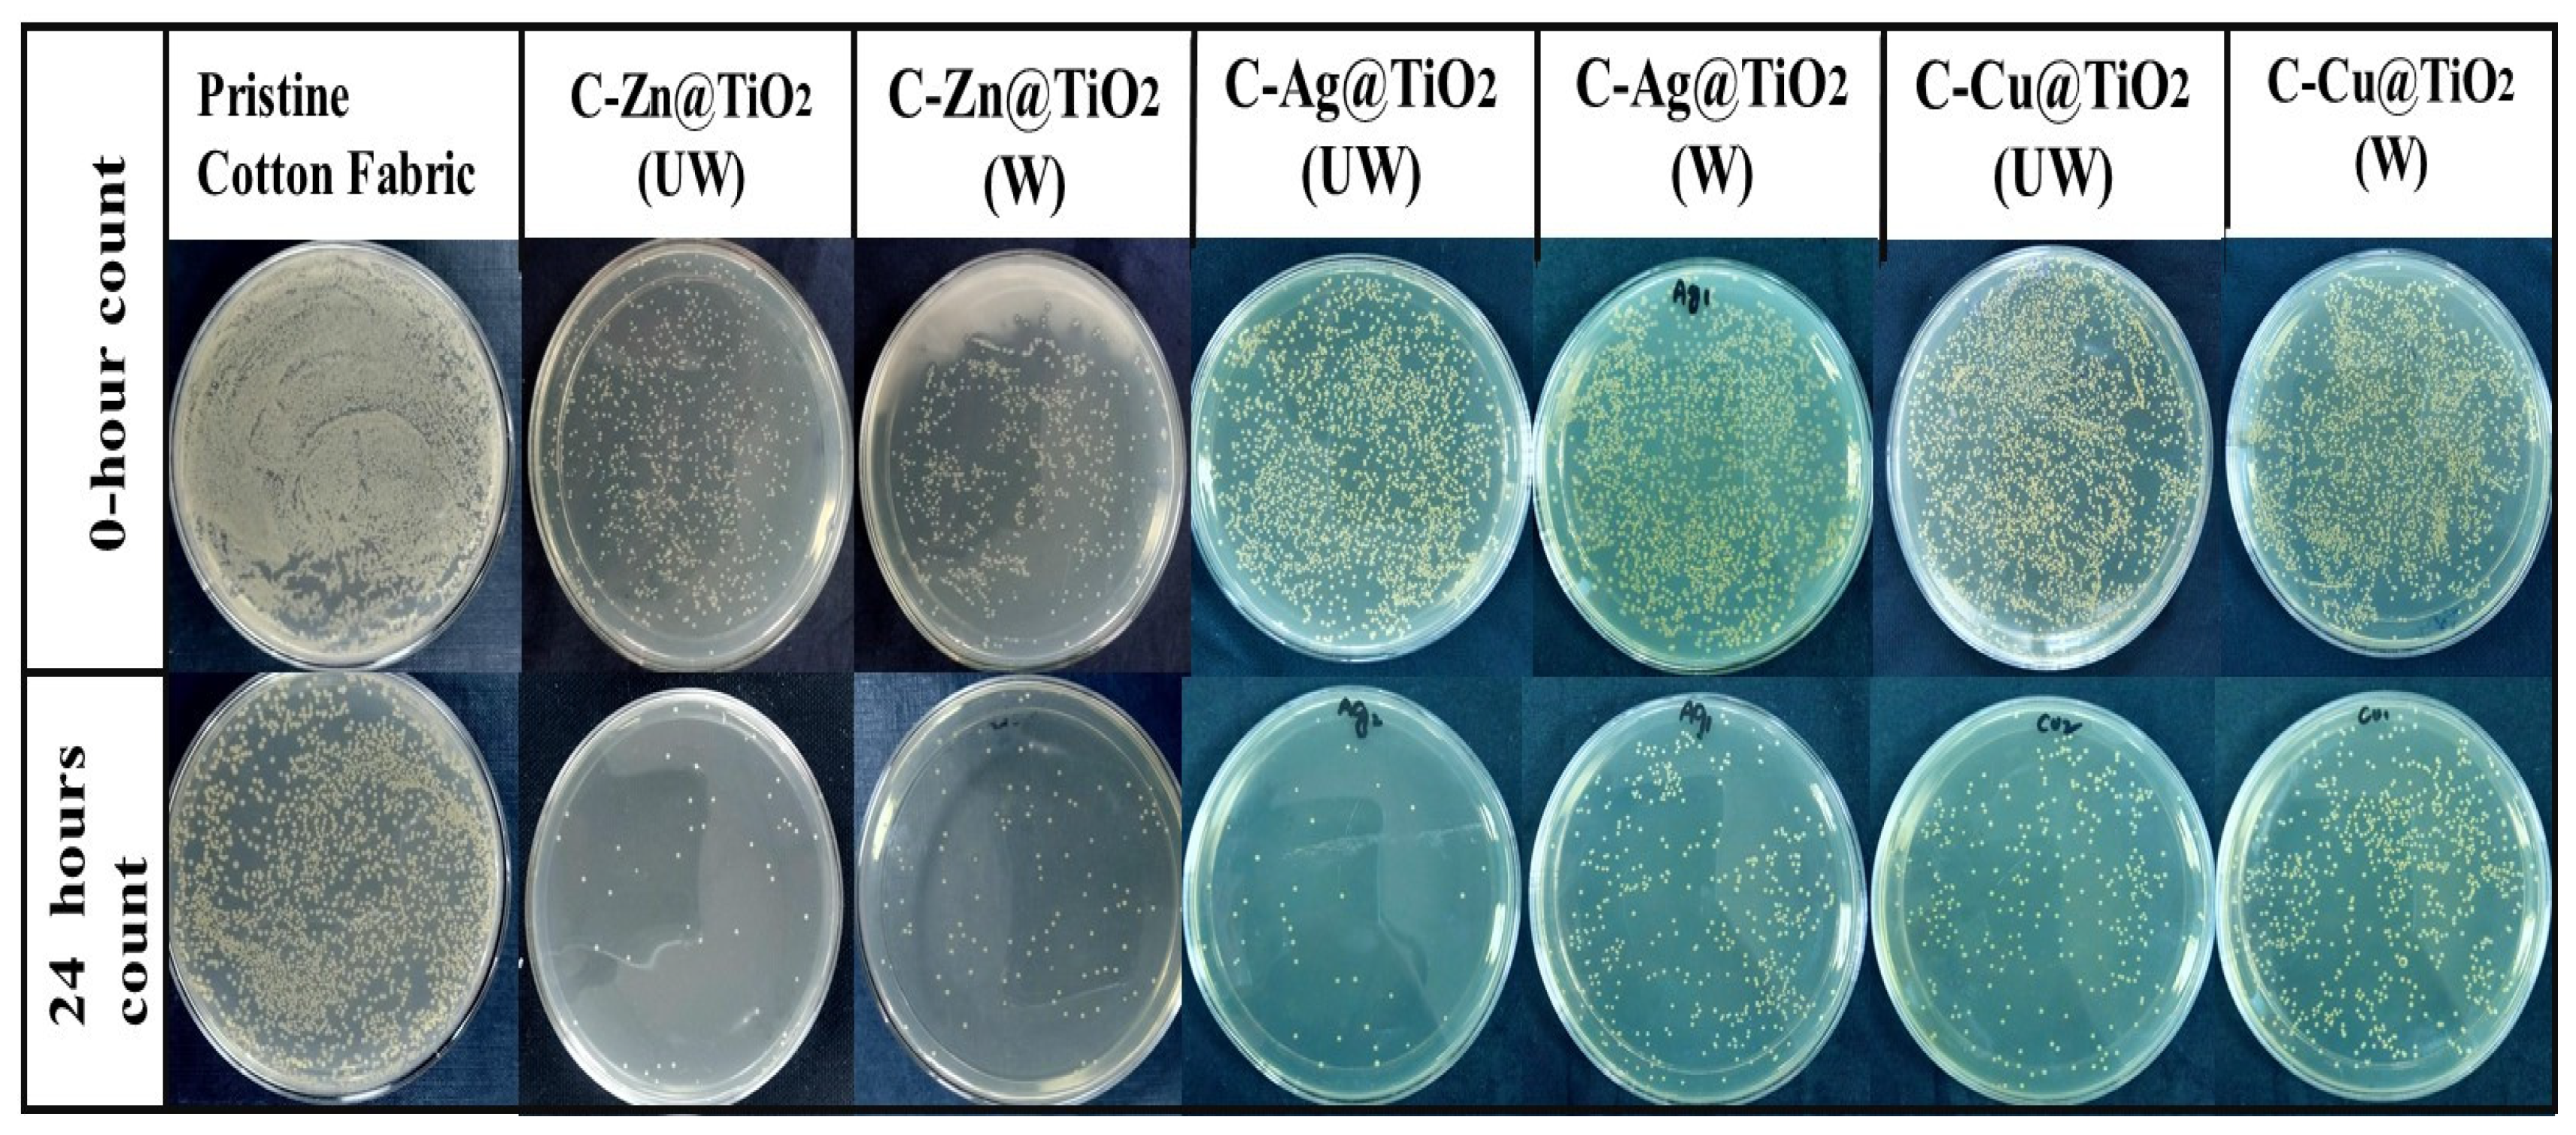
Catalysts 13 01293 g012

The Comparison of Metal Doped TiO2 Photocatalytic Active Fabrics under Sunlight for Waste Water Treatment Applications
Abstract
:1. Introduction
2. Results and Discussion
2.1. Morphological and Crystallographic Characterization
2.2. Chemical Characterization
2.3. Photocatalytic Degradation Experiment
2.4. Color Strength (K/S)
2.5. Antibacterial Activity Analysis and Washing Durability Test
2.6. Comfort Properties
3. Materials and Methods
3.1. Chemicals
3.2. Synthesis of TiO2 and Doped TiO2 NPs
3.3. Functionalization of Pristine TiO2 and Zn-, Ag- and Cu-Doped TiO2 NPs Using GPTS
3.4. Immobilization of TiO2 Nanoparticles on Cotton Fabric
3.5. Testing and Characterization
4. Conclusions
Author Contributions
Funding
Data Availability Statement
Acknowledgments
Conflicts of Interest
References
- Andrade, L.; O’Dwyer, J.; O’Neill, E.; Hynds, P. Surface water flooding, groundwater contamination, and enteric disease in developed countries: A scoping review of connections and consequences. Environ. Pollut. 2018, 236, 540–549. [Google Scholar] [CrossRef]
- Movalli, P.; Krone, O.; Osborn, D.; Pain, D. Monitoring contaminants, emerging infectious diseases and environmental change with raptors, and links to human health. Bird Study 2018, 65, S96–S109. [Google Scholar] [CrossRef]
- Kataria, N.; Garg, V. Application of EDTA modified Fe3O4/sawdust carbon nanocomposites to ameliorate methylene blue and brilliant green dye laden water. Environ. Res. 2019, 172, 43–54. [Google Scholar] [CrossRef] [PubMed]
- Lee, J.; Lee, D.; Lim, D.; Yang, K. Structural, electrical and optical properties of ZnO: Al films deposited on flexible organic substrates for solar cell applications. Thin Solid Films 2007, 515, 6094–6098. [Google Scholar] [CrossRef]
- Chequer, F.D.; De Oliveira, G.R.; Ferraz, E.A.; Cardoso, J.C.; Zanoni, M.B.; De Oliveira, D.P. Textile dyes: Dyeing process and environmental impact. In Eco-Friendly Textile Dyeing and Finishing; InTech: Houston, TX, USA, 2013; Volume 6, pp. 151–176. [Google Scholar]
- Zhang, P.; O’Connor, D.; Wang, Y.; Jiang, L.; Xia, T.; Wang, L.; Tsang, D.C.; Ok, Y.S.; Hou, D. A green biochar/iron oxide composite for methylene blue removal. J. Hazard. Mater. 2020, 384, 121286. [Google Scholar] [CrossRef]
- Wang, Y.; Zu, M.; Zhou, X.; Lin, H.; Peng, F.; Zhang, S. Designing efficient TiO2-based photoelectrocatalysis systems for chemical engineering and sensing. Chem. Eng. J. 2020, 381, 122605. [Google Scholar] [CrossRef]
- Ješić, D.; Jurković, D.L.; Pohar, A.; Suhadolnik, L.; Likozar, B. Engineering photocatalytic and photoelectrocatalytic CO2 reduction reactions: Mechanisms, intrinsic kinetics, mass transfer resistances, reactors and multi-scale modelling simulations. Chem. Eng. J. 2021, 407, 126799. [Google Scholar] [CrossRef]
- Sundar, K.P.; Kanmani, S. Progression of Photocatalytic reactors and it’s comparison: A Review. Chem. Eng. Res. Des. 2020, 154, 135–150. [Google Scholar] [CrossRef]
- Zhou, H.; Sheng, X.; Xiao, J.; Ding, Z.; Wang, D.; Zhang, X.; Liu, J.; Wu, R.; Feng, X.; Jiang, L. Increasing the Efficiency of Photocatalytic Reactions via Surface Microenvironment Engineering. J. Am. Chem. Soc. 2020, 142, 2738–2743. [Google Scholar] [CrossRef]
- Liu, D.; Chen, D.; Li, N.; Xu, Q.; Li, H.; He, J.; Lu, J. Surface engineering of g-C3N4 by stacked BiOBr sheets rich in oxygen vacancies for boosting photocatalytic performance. Angew. Chem. Int. Ed. 2020, 59, 4519–4524. [Google Scholar] [CrossRef] [PubMed]
- Ghosh, S.; Kouamé, N.A.; Ramos, L.; Remita, S.; Dazzi, A.; Deniset-Besseau, A.; Beaunier, P.; Goubard, F.; Aubert, P.-H.; Remita, H. Conducting polymer nanostructures for photocatalysis under visible light. Nat. Mater. 2015, 14, 505–511. [Google Scholar] [CrossRef] [PubMed]
- Meng, A.; Zhang, L.; Cheng, B.; Yu, J. Dual cocatalysts in TiO2 photocatalysis. Adv. Mater. 2019, 31, 1807660. [Google Scholar] [CrossRef]
- Tang, J.; Wang, R.; Liu, M.; Zhang, Z.; Song, Y.; Xue, S.; Zhao, Z.; Dionysiou, D.D. Construction of novel Z-scheme Ag/FeTiO3/Ag/BiFeO3 photocatalyst with enhanced visible-light-driven photocatalytic performance for degradation of norfloxacin. Chem. Eng. J. 2018, 351, 1056–1066. [Google Scholar] [CrossRef]
- Vidyasagar, D.; Ghugal, S.G.; Kulkarni, A.; Shende, A.G.; Umare, S.S.; Sasikala, R. Microwave assisted in situ decoration of a gC3N4 surface with CdCO3 nanoparticles for visible light driven photocatalysis. New J. Chem. 2018, 42, 6322–6331. [Google Scholar] [CrossRef]
- Ravichandran, K.; Sindhuja, E. Fabrication of cost effective g-C3N4+Ag activated ZnO photocatalyst in thin film form for enhanced visible light responsive dye degradation. Mater. Chem. Phys. 2019, 221, 203–215. [Google Scholar] [CrossRef]
- Xiao, M.; Wang, Z.; Lyu, M.; Luo, B.; Wang, S.; Liu, G.; Cheng, H.-M.; Wang, L. Hollow nanostructures for photocatalysis: Advantages and challenges. Adv. Mater. 2019, 31, 1801369. [Google Scholar] [CrossRef] [PubMed]
- Samokhvalov, A. Hydrogen by photocatalysis with nitrogen codoped titanium dioxide. Renew. Sustain. Energy Rev. 2017, 72, 981–1000. [Google Scholar] [CrossRef]
- Bakbolat, B.; Daulbayev, C.; Sultanov, F.; Beissenov, R.; Umirzakov, A.; Mereke, A.; Bekbaev, A.; Chuprakov, I. Recent Developments of TiO2-Based Photocatalysis in the Hydrogen Evolution and Photodegradation: A Review. Nanomaterials 2020, 10, 1790. [Google Scholar] [CrossRef] [PubMed]
- Yin, S.; Zhang, Q.; Saito, F.; Sato, T. Preparation of Visible Light-Activated Titania Photocatalyst by Mechanochemical Method. Chem. Lett. 2003, 32, 358–359. [Google Scholar] [CrossRef]
- Gao, B.; Yap, P.S.; Lim, T.M.; Lim, T.-T. Adsorption-photocatalytic degradation of Acid Red 88 by supported TiO2: Effect of activated carbon support and aqueous anions. Chem. Eng. J. 2011, 171, 1098–1107. [Google Scholar] [CrossRef]
- Mallakpour, S.; Nikkhoo, E. Surface modification of nano-TiO2 with trimellitylimido-amino acid-based diacids for pre-venting aggregation of nanoparticles. Adv. Powder Technol. 2014, 25, 348–353. [Google Scholar] [CrossRef]
- Minero, C.; Vione, D. A quantitative evalution of the photocatalytic performance of TiO2 slurries. Appl. Catal. B Environ. 2006, 67, 257–269. [Google Scholar] [CrossRef]
- Dong, F.; Guo, S.; Wang, H.; Li, X.; Wu, Z. Enhancement of the visible light photocatalytic activity of C-doped TiO2 nanomaterials prepared by a green synthetic approach. J. Phys. Chem. C 2011, 115, 13285–13292. [Google Scholar] [CrossRef]
- Lightcap, I.V.; Kosel, T.H.; Kamat, P.V. Anchoring semiconductor and metal nanoparticles on a two-dimensional catalyst mat. Storing and shuttling electrons with reduced graphene oxide. Nano Lett. 2010, 10, 577–583. [Google Scholar]
- Makarova, O.V.; Rajh, T.; Thurnauer, M.C.; Martin, A.; Kemme, P.A.; Cropek, D. Surface modification of TiO2 nanoparticles for photochemical reduction of nitrobenzene. Environ. Sci. Technol. 2000, 34, 4797–4803. [Google Scholar] [CrossRef]
- Gad-Allah, T.A.; Kato, S.; Satokawa, S.; Kojima, T. Role of core diameter and silica content in photocatalytic activity of TiO2/SiO2/Fe3O4 composite. Solid State Sci. 2007, 9, 737–743. [Google Scholar] [CrossRef]
- Tang, Y.; Zhang, G.; Liu, C.; Luo, S.; Xu, X.; Chen, L.; Wang, B. Magnetic TiO2-graphene composite as a high-performance and recyclable platform for efficient photocatalytic removal of herbicides from water. J. Hazard. Mater. 2013, 252, 115–122. [Google Scholar] [CrossRef]
- Madubuonu, N.; Aisida, S.O.; Ahmad, I.; Botha, S.; Zhao, T.-K.; Maaza, M.; Ezema, F.I. Bio-inspired iron oxide nanoparticles using Psidium guajava aqueous extract for antibacterial activity. Appl. Phys. A 2020, 126, 72. [Google Scholar] [CrossRef]
- Shafi, A.; Ahmad, N.; Sultana, S.; Sabir, S.; Khan, M.Z. Ag2S-Sensitized NiO-ZnO Heterostructures with Enhanced Visible Light Photocatalytic Activity and Acetone Sensing Property. ACS Omega 2019, 4, 12905–12918. [Google Scholar] [CrossRef]
- Grabowska, E.; Zaleska, A.; Sorgues, S.; Kunst, M.; Etcheberry, A.; Colbeau-Justin, C.; Remita, H. Modification of Titanium (IV) Dioxide with Small Silver Nanoparticles: Application in Photocatalysis. J. Phys. Chem. C 2013, 117, 1955–1962. [Google Scholar] [CrossRef]
- Qamar, M.A.; Shahid, S.; Javed, M.; Shariq, M.; Fadhali, M.M.; Madkhali, O.; Ali, S.K.; Syed, I.S.; Awaji, M.Y.; Shakir Khan, M.; et al. Accelerated Decoloration of Organic Dyes from Wastewater Using Ternary Metal/g-C3N4/ZnO Nanocomposites: An Investigation of Impact of g-C3N4 Concentration and Ni and Mn Doping. Catalysts 2022, 12, 1388. [Google Scholar] [CrossRef]
- Javed, M.; Iqbal, S.; Qamar, M.A.; Shariq, M.; Ahmed, I.A.; BaQais, A.; Alzahrani, H.; Ali, S.K.; Masmali, N.A.; Althagafi, T.M.; et al. Fabrication of Effective Co-SnO2/SGCN Photocatalysts for the Removal of Organic Pollutants and Pathogen Inactivation. Crystals 2023, 13, 163. [Google Scholar] [CrossRef]
- Wang, A.; Wu, S.; Dong, J.; Wang, R.; Wang, J.; Zhang, J.; Zhong, S.; Bai, S. Interfacial facet engineering on the Schottky barrier between plasmonic Au and TiO2 in boosting the photocatalytic CO2 reduction under ultraviolet and visible light irradiation. Chem. Eng. J. 2021, 404, 127145. [Google Scholar] [CrossRef]
- Guan, Y.; Wu, J.; Man, X.; Liu, Q.; Qi, Y.; He, P.; Qi, X. Rational fabrication of flower-like BiOI1-x photocatalyst by modulating efficient iodine vacancies for mercury removal and DFT study. Chem. Eng. J. 2020, 396, 125234. [Google Scholar] [CrossRef]
- Arunachalam, A.; Dhanapandian, S.; Manoharan, C.; Sivakumar, G. Physical properties of Zn doped TiO2 thin films with spray pyrolysis technique and its effects in antibacterial activity. Spectrochim. Acta Part A Mol. Biomol. Spectrosc. 2015, 138, 105–112. [Google Scholar] [CrossRef] [PubMed]
- Jing, L.; Xin, B.; Yuan, F.; Xue, L.; Wang, B.; Fu, H. Effects of Surface Oxygen Vacancies on Photophysical and Photochemical Processes of Zn-Doped TiO2 Nanoparticles and Their Relationships. J. Phys. Chem. B 2006, 110, 17860–17865. [Google Scholar] [CrossRef] [PubMed]
- Gupta, K.; Singh, R.; Pandey, A.; Pandey, A. Photocatalytic antibacterial performance of TiO2 and Ag-doped TiO2 against S. aureus. P. aeruginosa and E. coli. Beilstein J. Nanotechnol. 2013, 4, 345–351. [Google Scholar] [CrossRef]
- Bensouici, F.; Bououdina, M.; Dakhel, A.; Tala-Ighil, R.; Tounane, M.; Iratni, A.; Souier, T.; Liu, S.; Cai, W. Optical, structural and photocatalysis properties of Cu-doped TiO2 thin films. Appl. Surf. Sci. 2017, 395, 110–116. [Google Scholar] [CrossRef]
- Sanakousar, F.; Vidyasagar, C.; Jiménez-Pérez, V.; Prakash, K. Recent progress on visible-light-driven metal and non-metal doped ZnO nanostructures for photocatalytic degradation of organic pollutants. Mater. Sci. Semicond. Process. 2022, 140, 106390. [Google Scholar] [CrossRef]
- Abbas, M.M.; Rasheed, M. Solid State Reaction Synthesis and Characterization of Aluminum Doped Titanium Dioxide Nanomaterials. J. Southwest Jiaotong Univ. 2020, 55, 2. [Google Scholar] [CrossRef]
- Kumar, S.; Verma, N.K.; Singla, M.L. Study on reflectivity and photostability of Al-doped TiO2 nanoparticles and their reflectors. J. Mater. Res. 2013, 28, 521–528. [Google Scholar] [CrossRef]
- Lin, S.-S.; Wu, D.-K. Enhanced optical properties of Al-doped TiO2 thin films in oxygen or nitrogen atmosphere. Appl. Surf. Sci. 2009, 255, 8654–8659. [Google Scholar] [CrossRef]
- Basavarajappa, P.S.; Patil, S.B.; Ganganagappa, N.; Reddy, K.R.; Raghu, A.V.; Reddy, C.V. Recent progress in metal-doped TiO2, non-metal doped/codoped TiO2 and TiO2 nanostructured hybrids for enhanced photocatalysis. Int. J. Hydrogen Energy 2020, 45, 7764–7778. [Google Scholar] [CrossRef]
- Qi, K.; Xing, X.; Zada, A.; Li, M.; Wang, Q.; Liu, S.-y.; Lin, H.; Wang, G. Transition metal doped ZnO nanoparticles with enhanced photo-catalytic and antibacterial performances: Experimental and DFT studies. Ceram. Int. 2020, 46, 1494–1502. [Google Scholar] [CrossRef]
- Rehman, A.U.; Aadil, M.; Zulfiqar, S.; Agboola, P.O.; Shakir, I.; Aboud, M.F.A.; Haider, S.; Warsi, M.F. Fabrication of binary metal doped CuO nanocatalyst and their application for the industrial effluents treatment. Ceram. Int. 2021, 47, 5929–5937. [Google Scholar] [CrossRef]
- Lee, S.; Noh, J.H.; Han, H.S.; Yim, D.K.; Kim, D.H.; Lee, J.-K.; Kim, J.Y.; Jung, H.S.; Hong, K.S. Nb-doped TiO2: A new compact layer material for TiO2 dye-sensitized solar cells. J. Phys. Chem. C 2009, 113, 6878–6882. [Google Scholar] [CrossRef]
- Ismael, M. A review and recent advances in solar-to-hydrogen energy conversion based on photocatalytic water splitting over doped-TiO2 nanoparticles. Solar Energy 2020, 211, 522–546. [Google Scholar] [CrossRef]
- Chong, W.-K.; Ng, B.-J.; Kong, X.Y.; Tan, L.-L.; Putri, L.K.; Chai, S.-P. Non-metal doping induced dual p-n charge properties in a single ZnIn2S4 crystal structure provoking charge transfer behaviors and boosting photocatalytic hydrogen generation. Appl. Catal. B Environ. 2023, 325, 122372. [Google Scholar] [CrossRef]
- Yu, J.; Yu, H.; Ao, C.; Lee, S.; Yu, J.C.; Ho, W. Preparation, characterization and photocatalytic activity of in situ Fe-doped TiO2 thin films. Thin Solid Films 2006, 496, 273–280. [Google Scholar] [CrossRef]
- Hu, Y.; Song, X.; Jiang, S.; Wei, C. Enhanced photocatalytic activity of Pt-doped TiO2 for NOx oxidation both under UV and visible light irradiation: A synergistic effect of lattice Pt4+ and surface PtO. Chem. Eng. J. 2015, 274, 102–112. [Google Scholar] [CrossRef]
- Peng, H.; Guo, R.; Lin, H. Photocatalytic reduction of CO2 over Sm-doped TiO2 nanoparticles. J. Rare Earths 2020, 38, 1297–1304. [Google Scholar] [CrossRef]
- Larumbe, S.; Monge, M.; Gómez-Polo, C. Comparative study of (N, Fe) doped TiO2 photocatalysts. Appl. Surf. Sci. 2015, 327, 490–497. [Google Scholar] [CrossRef]
- Yang, X.-J.; Wang, S.; Sun, H.-M.; Wang, X.-B.; Lian, J.-S. Preparation and photocatalytic performance of Cu-doped TiO2 nanoparticles. Trans. Nonferrous Met. Soc. China 2015, 25, 504–509. [Google Scholar] [CrossRef]
- Liu, J.; Hodes, G.; Yan, J.; Liu, S.F. Metal-doped Mo2C (metal = Fe, Co, Ni, Cu) as catalysts on TiO2 for photocatalytic hydrogen evolution in neutral solution. Chin. J. Catal. 2021, 42, 205–216. [Google Scholar] [CrossRef]
- Patil, S.B.; Basavarajappa, P.S.; Ganganagappa, N.; Jyothi, M.; Raghu, A.; Reddy, K.R. Recent advances in non-metals-doped TiO2 nanostructured photocatalysts for visible-light driven hydrogen production, CO2 reduction and air purification. Int. J. Hydrog. Energy 2019, 44, 13022–13039. [Google Scholar] [CrossRef]
- Yan, X.; Jin, Z. Interface engineering: NiAl-LDH in-situ derived NiP2 quantum dots and Cu3P nanoparticles ingeniously constructed pn heterojunction for photocatalytic hydrogen evolution. Chem. Eng. J. 2021, 420, 127682. [Google Scholar] [CrossRef]

| Nature of Dopant | Doped TiO2 Synthesis Route | Doped TiO2 Loading (g/L) | Optimum Calcination Range (°C) | Organic Pollutant | Initial Pollutant Conc (mg/L) | Light Source | Deg Efficiency (%) | Ref. |
|---|---|---|---|---|---|---|---|---|
| Fe Mobile phase | Solgel | 5.0 | 400 | Methyl orange | 20 | UV–vis | 99.7 | [50] |
| Pt Mobile phase | Photochemical reduction | 2.0 | 110 | Methyl orange | 20 | UV | 87.7 | [51] |
| I, F Mobile phase | Solgel-impregnation | 1.0 | 500 | Methylene blue | 10 | Sunlight | 98 | [51] |
| Sm, N Mobile phase | Coprecipitation | 1.0 | 400 | Nitrate | 50 | UV-vis | 67 | [52] |
| Fe Mobile phase | Solgel | 0.02 | 450 | Phenol | 70 | Ultrasonic | 83 | [53] |
| Cu, S Mobile phase | Hydrolysis | 1.0 | 400 | Methyl orange | 350 | Sunlight | 65 | [54] |
| Pt, Cu Mobile phase | Solgel | 1.0 | 400 | Methylene blue | 10 | UV | 93 | [54] |
| Cu, Ag and Zn Passivated | Sol–gel | 1, 2 and 4 mol% | 400 | Multiple | 10 | Sunlight | 80–90% | Our work |
| Fabric | Dye | % Red | Fabric | Dye | % Reduction |
|---|---|---|---|---|---|
| C-Zn@TiO2 | MB MO R Y NB | 96 88 85 83 89 | C-Ag@TiO2 | MB MO R Y NB | 94 76 83 76 91 |
| C-Cu@TiO2 | MB MO R Y NB | 90 63 90 75 93 | C-TiO2 | MB MO R Y NB | 47 45 31 34 54 |
| Control | MB MO R Y NB | 51 46 28 36 49 | |||
Disclaimer/Publisher’s Note: The statements, opinions and data contained in all publications are solely those of the individual author(s) and contributor(s) and not of MDPI and/or the editor(s). MDPI and/or the editor(s) disclaim responsibility for any injury to people or property resulting from any ideas, methods, instructions or products referred to in the content. |
© 2023 by the authors. Licensee MDPI, Basel, Switzerland. This article is an open access article distributed under the terms and conditions of the Creative Commons Attribution (CC BY) license (https://creativecommons.org/licenses/by/4.0/).
Share and Cite
Lee, K.H.; Arfa, U.; Arshad, Z.; Lee, E.-J.; Alshareef, M.; Alsowayigh, M.M.; Shahid, K.; Shahid, R.; Hamad, N. The Comparison of Metal Doped TiO2 Photocatalytic Active Fabrics under Sunlight for Waste Water Treatment Applications. Catalysts 2023, 13, 1293. https://doi.org/10.3390/catal13091293
Lee KH, Arfa U, Arshad Z, Lee E-J, Alshareef M, Alsowayigh MM, Shahid K, Shahid R, Hamad N. The Comparison of Metal Doped TiO2 Photocatalytic Active Fabrics under Sunlight for Waste Water Treatment Applications. Catalysts. 2023; 13(9):1293. https://doi.org/10.3390/catal13091293
Chicago/Turabian StyleLee, Kang Hoon, Ume Arfa, Zafar Arshad, Eui-Jong Lee, Mubark Alshareef, Marwah M. Alsowayigh, Kinza Shahid, Raghisa Shahid, and N. Hamad. 2023. "The Comparison of Metal Doped TiO2 Photocatalytic Active Fabrics under Sunlight for Waste Water Treatment Applications" Catalysts 13, no. 9: 1293. https://doi.org/10.3390/catal13091293
APA StyleLee, K. H., Arfa, U., Arshad, Z., Lee, E.-J., Alshareef, M., Alsowayigh, M. M., Shahid, K., Shahid, R., & Hamad, N. (2023). The Comparison of Metal Doped TiO2 Photocatalytic Active Fabrics under Sunlight for Waste Water Treatment Applications. Catalysts, 13(9), 1293. https://doi.org/10.3390/catal13091293

